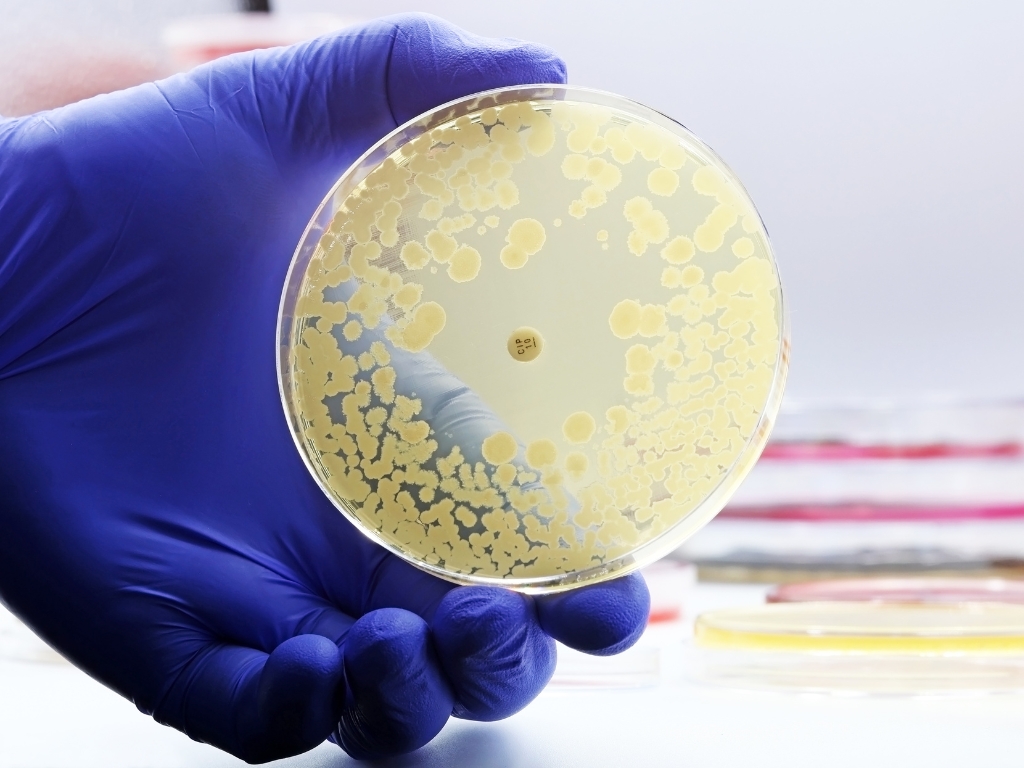
bakteria - Canva

Do chorych nie mogą przychodzić osoby z objawami infekcji górnych dróg oddechowych. Przy łóżku pacjenta może być tylko jedna osoba. Wyznaczono też określone godziny odwiedzin. Dodatkowe ograniczenia dotyczą wizyt w izolatkach. Na salę można wejść maksymalnie na 5 minut. Przed wejściem odwiedzający musi założyć jednorazowe rękawiczki i jednorazowy fartuch.
New Delhi to bakteria odporna na większość antybiotyków. W szpitalu wykryto ją w sumie u 10 pacjentów. Żaden nie miał objawów. Chorzy zostali odizolowani, a ci, których stan zdrowia na to pozwalał, wypisani do domów.
Szpital i Sanepid prowadzą dochodzenie epidemiologiczne w sprawie ogniska i ustalają, gdzie mogło dojść do zakażenia.










